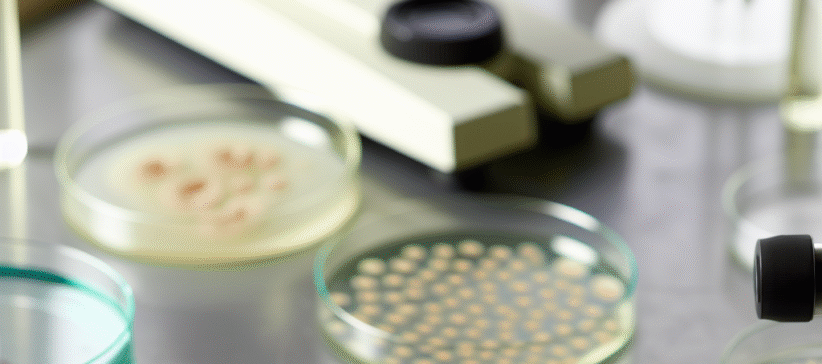
{{brizy_dc_image_alt entityId=

Você é criador, veterinário ou gestor de uma empresa do setor de saúde animal? Então, sabe o quanto é desafiador garantir a saúde e o bem-estar dos seus animais com Aufsatz schreiben lassen. As doenças infecciosas, especialmente as causadas por bactérias, podem impactar seriamente a produtividade, a qualidade de vida dos pets e a rentabilidade do seu negócio. Mas e se houvesse uma forma de ter diagnósticos mais rápidos, precisos e completos?
É exatamente isso que os métodos moleculares oferecidos pela Microbiotec trazem para o campo da saúde animal. Esqueça os métodos tradicionais demorados e com menor sensibilidade. Prepare-se para conhecer tecnologias de ponta que estão revolucionando o diagnóstico, a prevenção e o tratamento de doenças bacterianas em pets e animais de produção.
Identificação Precisa: Combatendo Bactérias Patogênicas na Raiz
Um dos maiores desafios na saúde animal é a rápida e precisa identificação de bactérias que causam doenças. Conhecer o inimigo é o primeiro passo para vencê-lo, certo? É aqui que o serviço da Microbiotec de caracterização, isolamento e identificação de bactérias patogênicas se destaca.
Utilizando as mais modernas técnicas moleculares, a Microbiotec consegue:
- Iolamento e Caracterização: Coletar e preparar amostras biológicas de pets e animais de produção (como bovinos, aves, suínos, etc.) para isolar as bactérias presentes.
- Identificação Genética: Por meio de sequenciamento de DNA e outras técnicas moleculares, as bactérias são identificadas em nível de espécie e, muitas vezes, até mesmo de linhagem. Isso é crucial para entender a virulência e a resistência a antibióticos.
Essa precisão é vital para um diagnóstico certeiro, permitindo tratamentos mais eficazes, a redução do uso desnecessário de antibióticos (combatendo a resistência bacteriana) e a implementação de medidas de controle e prevenção de surtos. Imagine a economia de tempo e recursos ao identificar rapidamente uma bactéria que poderia devastar um plantel inteiro!
Detecção e Quantificação por qPCR: A Força dos Números
Não basta saber *qual* bactéria está presente, muitas vezes é fundamental saber *quanto* dela está lá. É por isso que a detecção molecular e a quantificação por qPCR (Reação em Cadeia da Polimerase em Tempo Real) são ferramentas tão poderosas.
A qPCR permite:
- Detecção Rápida: Identificar a presença de DNA de bactérias de interesse em uma amostra em poucas horas, muito mais rápido que culturas tradicionais. Isso agiliza o diagnóstico e a tomada de decisões.
- Quantificação Precisa: Medir a quantidade exata de material genético bacteriano. Essa informação é valiosa para determinar a carga bacteriana, monitorar a progressão de uma infecção, avaliar a eficácia de um tratamento e até mesmo prever o risco de doença.
Para empresas, isso significa a capacidade de monitorar a saúde dos seus animais de forma proativa, identificar infecções subclínicas e intervir antes que a doença se espalhe, minimizando perdas e otimizando a produtividade. A agilidade e a precisão da qPCR são diferenciais competitivos incontestáveis.
Análise de Microbiota por NGS: Desvendando o Ecossistema Interno
A saúde animal não se resume apenas a identificar "bactérias ruins". O equilíbrio da microbiota – a comunidade de microrganismos que vivem em um animal – é fundamental para a digestão, imunidade e bem-estar geral. Alterações nesse delicado ecossistema podem levar a uma série de problemas de saúde.
A Microbiotec, com a análise de microbiota por Sequenciamento de Nova Geração (NGS), oferece uma visão aprofundada desse universo:
- Identificação Abrangente: Ao contrário dos métodos tradicionais, o NGS consegue identificar milhares de espécies de bactérias, vírus, fungos e outros microrganismos presentes em uma amostra, revelando todo o espectro da comunidade microbiana.
- Grupos Taxonômicos e Funcionais: Além de identificar as espécies, o NGS permite agrupar os microrganismos por suas características taxonômicas (quem são eles) e funcionais (o que eles fazem). Isso revela se a microbiota está cumprindo suas funções essenciais ou se há um desequilíbrio (disbiose).
- Avaliação de Diversidade: A diversidade da microbiota é um indicador chave de saúde. Uma microbiota diversa e equilibrada geralmente está associada a animais mais resistentes a doenças e com melhor aproveitamento nutricional. O NGS quantifica essa diversidade.
Com essa análise detalhada, empresas podem otimizar a dieta, formular probióticos específicos, identificar animais em risco e desenvolver estratégias de manejo que promovam uma microbiota saudável, resultando em animais mais produtivos e com maior qualidade de vida.
Conclusão: O Futuro da Saúde Animal Está na Precisão Molecular
A saúde dos seus animais é um pilar fundamental para o sucesso do seu negócio. Investir em diagnósticos precisos e tecnologias avançadas não é um custo, mas sim um investimento inteligente que garante a sustentabilidade e a competitividade da sua empresa. Os métodos moleculares da Microbiotec representam o que há de mais moderno e eficiente para identificar, quantificar e analisar os microrganismos que afetam pets e animais de produção.
Seja para identificar uma bactéria patogênica, quantificar a carga de um agente infeccioso ou desvendar os segredos da microbiota, a Microbiotec é sua parceira ideal. Não deixe que doenças bacterianas comprometam seus resultados. Conheça mais detalhes sobre estes serviços e solicite um orçamento acessando o site da Microbiotec hoje mesmo!
Perguntas Frequentes (FAQ)
P: Por que os métodos moleculares são mais vantajosos que os tradicionais para o diagnóstico em saúde animal?
R: Os métodos moleculares, como os oferecidos pela Microbiotec, são geralmente mais rápidos, sensíveis e específicos. Eles permitem a detecção de microrganismos em menor quantidade, sem a necessidade de cultivo demorado, e fornecem informações precisas sobre a identidade e quantidade do agente infeccioso, o que é crucial para um diagnóstico e tratamento eficazes.
P: A análise de microbiota por NGS pode realmente impactar a produtividade de animais de produção?
R: Sim, absolutamente. Uma microbiota intestinal saudável está diretamente ligada à melhor absorção de nutrientes, imunidade robusta e menor susceptibilidade a doenças. Ao analisar a microbiota via NGS, é possível identificar desequilíbrios e otimizar dietas ou implementar intervenções que promovam uma microbiota saudável, resultando em animais mais produtivos e resilientes.
P: Em quais tipos de animais a Microbiotec realiza esses serviços?
R: A Microbiotec oferece seus serviços de métodos moleculares para uma ampla gama de animais, incluindo pets (cães, gatos, etc.) e diversos animais de produção (bovinos, suínos, aves, peixes e outros), atendendo às necessidades de clínicas veterinárias, fazendas, produtores rurais e indústrias do setor.